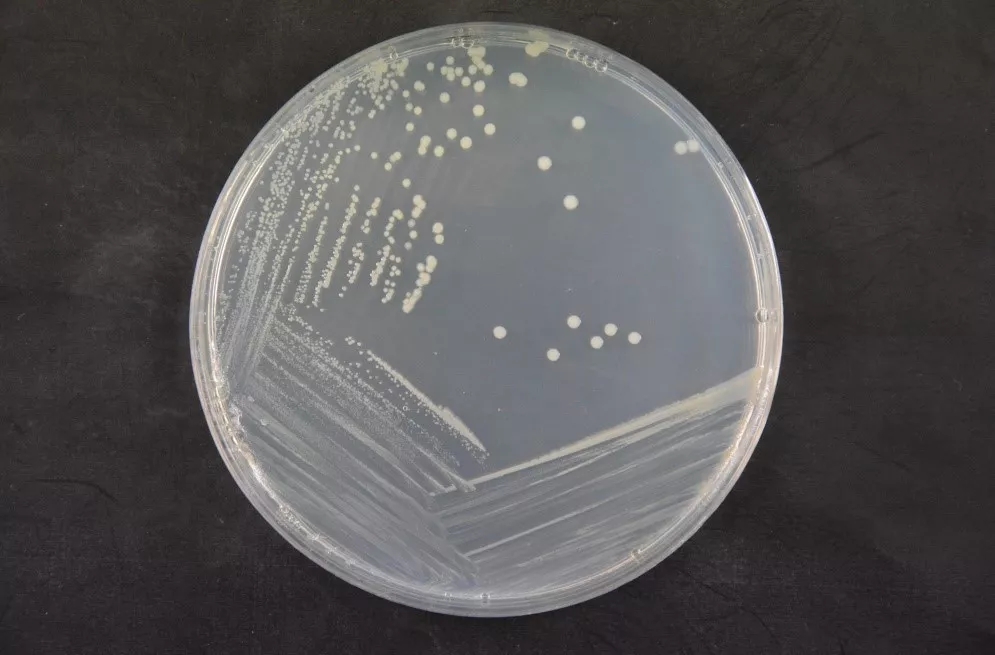

海博微信公众号
海博微信公众号
 海博天猫旗舰店
海博天猫旗舰店


 海博微信公众号
海博微信公众号
 海博天猫旗舰店
海博天猫旗舰店




椰毒假单胞酵母菌酵米面亚种Pseudomonas cocovenenans subsp. farinofermentans是一种存在于酵米面、变质鲜银耳及其他淀粉类发酵产品中的食源性致病菌,1977年从我国东北酵米面中毒食品中被分离出来。1994年,首个椰毒假单胞菌酵米面亚种检验国家标准 GB/T 4789.29颁布并实施, 目前现行标准GB/T 4789.29-2003《食品卫生微生物学检验 椰毒假单胞菌酵米面亚种检验》。
由于椰毒假单胞酵母菌酵米面亚种不是国际公开发表和承认的细菌分类科学名称,因此给标准的正确实施造成了很大困扰。近些年来,研究人员对椰毒假单胞菌酵米面亚种的分类和命名进行了研究,于1999年将其划分为唐菖蒲伯克霍尔德氏菌Burkholderia gladioli的一个病原型,因此2018年9月国家卫生健康委员会发布的《食品安全国家标准 食品微生物学检验 唐菖蒲伯克霍尔德氏菌(椰毒假单胞菌酵米面亚种)检验(征求意见稿)》中,将该菌种进行了更名。
形态学
CICC根据该标准征求意见稿要求,对中心保藏的CICC 10574唐菖蒲伯克霍尔德氏菌关键性能进行了检测,结果表明符合标准典型特征描述,可作为该标准检测用标准菌株,相关数据如下:
显微形态

菌落形态
|
|
|
|
mPDA培养基36 ℃±1 ℃,24 h, 菌落1 mm~2 mm,紫色,光滑、湿润、边缘整齐。
|
mPDA培养基继续培养至4d后, 部分菌落中心可有凸起呈草帽状
|
|
|
|
|
卵黄琼脂平板,36 ℃±1 ℃培养18 h, 菌落2 mm~3 mm,表面光滑、湿润。 |
培养4d后,菌落周围形成乳白色混浊环, 斜射光下可见菌落及周围培养基表面呈虹彩现象 |
生化实验结果
VITEK鉴定结果

生化鉴定结果

注:*:与标准征求意见稿中不一致。
API鉴定结果

上一篇:微生物菌图形态检查操作指导



